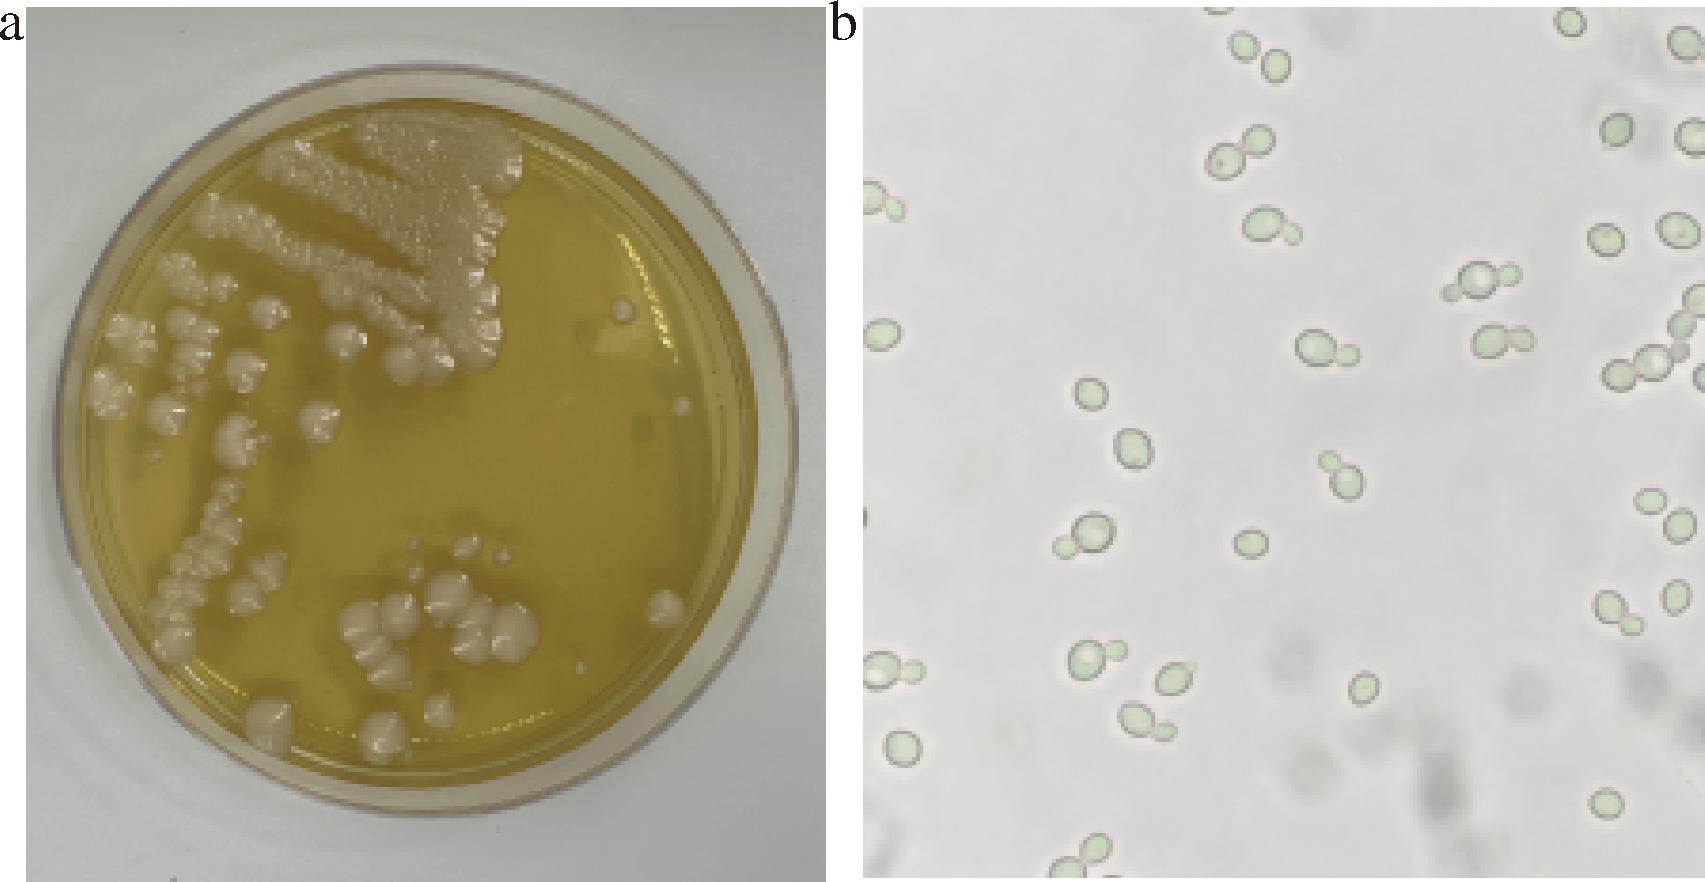

硒是人体所必需的微量元素,具有多种生物学功能,包括增强生殖功能和免疫力等[1-2],长期缺硒还会导致包括克山病、糖尿病、大骨节病、心脑血管病等多种疾病的发生[3]。由于硒无法由人体自身合成,因此必须通过日常饮食来摄取[4]。然而,自然界中的硒主要以无机硒的形态存在,这种形态的硒具有较强的毒性,并且在人体中的吸收利用率较低。相对而言,有机硒的吸收利用率更高,不仅易于被人体吸收,且毒性相对较低[5]。因此,为了维护人体健康,适当补充有机硒显得尤为重要。
常见的有机硒补充剂包括富硒酵母、硒蛋白、硒多糖等,其中富硒酵母是目前应用最为广泛的一种食品级有机硒补充剂,具有低毒、易于生产等优点[6]。自然界中的酵母具有富硒量不稳定、生物量较低等缺点,但可以通过菌种筛选、菌种诱变及优化发酵条件等方法提高酵母的富硒量及生物量。杨新等[7]通过耐硒法与红硒法进行筛选,并最终得到富硒量为2 278.35 μg/g,生物量为4.31 g/L的酿酒酵母菌株;马楚楚等[8]以产朊假丝酵母为出发菌株,优化摇瓶培养条件,最终菌体有机硒含量为1 400.36 μg/g;贺莹等[9]采用响应面法优化富硒酵母的发酵工艺,最终获得的酵母生物量为17.53 g/L,富硒量为1 420 μg/g。因此,经过菌种筛选、菌种诱变及优化发酵条件后的富硒酵母具有高富硒量、高生物量等优点,是一种理想的有机硒补充剂。
作为有机硒补充剂,富硒酵母展现出显著的抗氧化能力。硒是谷胱甘肽过氧化物酶(glutathione peroxidase,GSH-Px)的活性中心,富硒酵母中的硒元素能够有效地提高GSH-Px的活性,从而增强机体的抗氧化能力。张斌[10]的研究发现,富硒酵母对超氧阴离子自由基、过氧化氢自由基及羟自由基具有良好的清除效果,其清除效率随着富硒酵母浓度的增加而增强。此外,冯星等[11]的研究显示,在奶牛饲料中添加富硒酵母,可以提升奶牛的免疫力及血清抗氧化能力。富硒酵母不仅在动物营养方面展现出应用前景,同时也为开发抗氧化剂提供了新的思路与方向。
富硒酵母发酵工艺优化在实验室大多采用酵母浸出粉胨葡萄糖(yeast extract peptone dextrose,YPD)培养基摇瓶发酵,而选择使用糖蜜培养基的鲜有报道,因此,运用糖蜜培养基对富硒酵母发酵工艺进行优化,有利于推动富硒酵母的产业发展。本研究运用红硒法及耐硒法相结合,旨在筛选出适用于工业化生产的富硒酵母菌株,并以糖蜜培养基为富硒发酵基础培养基,通过优化发酵工艺来提高酵母的富硒量与生物量,以期为富硒酵母的规模化、高效化工业生产提供理论技术支持以及数据支撑。
1 材料与方法
1.1 材料与试剂
1.1.1 菌株
前期从果蔬及土壤样品中分离出的35株酵母菌株,保藏于安徽科技学院食品安全实验室-80 ℃冰箱。
1.1.2 试剂
3,3′-二氨基联苯胺,上海捷世凯生物科技有限公司;亚硒酸钠,上海绿源精细化工有限公司;浓盐酸,国药集团化学试剂有限公司;硫酸铵、硫酸镁,天津市永大化学试剂有限公司;二甲苯,蚌埠化学试剂厂。以上化学试剂均为分析纯。
1.1.3 培养基
YPD液体培养基(g/L):蛋白胨20.0、酵母浸出粉10.0、葡萄糖20.0,自然pH,121 ℃高压灭菌20 min,YPD固体培养基另加琼脂20.0。
糖蜜培养基(g/L):稀释处理后糖蜜:25 °Bx、硫酸铵3.0、磷酸二氢钾1.1、硫酸镁2.0、盐酸硫胺0.008、生物素0.000 4,115 ℃灭菌20 min。
硒母液(1 000 μg/mL):称取2.19 g亚硒酸钠溶解于1 000 mL无菌水中,滤膜过滤除菌。
1.2 仪器与设备
SF-CJ-2A超净工作台,上海三发科学仪器有限公司;LGJ-30FD真空冷冻干燥机,北京松源华兴科技发展有限公司;LDZX-50KBS立式高压蒸汽灭菌锅,上海申安医疗器械厂;L550低速台式离心机,湖南湘仪实验室仪器开发有限公司。
1.3 实验方法
1.3.1 糖蜜预处理
将糖蜜用蒸馏水稀释至(25±5) °Bx,调节pH值至4.5,加热煮沸30 min,调节pH值至5.0,在75 ℃条件下恒温静置8 h以上,取上清液。
1.3.2 菌种的初筛
红硒法:将酵母菌株接种至硒质量浓度为25 μg/mL的YPD固体培养基,置于培养箱中30 ℃恒温培养2~3 d,观察酵母菌体颜色。
耐硒法:以5%的接种量将酵母菌接种至YPD液体培养基中,30 ℃、180 r/min培养12 h后加入硒母液,使得培养基中硒质量浓度为10~50 μg/mL,并继续发酵24 h,发酵结束后5 000 r/min离心8 min,并用去离子水洗涤菌体2~3次,观察酵母菌体颜色及生物量。
1.3.3 菌种的复筛
将筛选出的酵母菌株以5%的接种量接种至糖蜜基础培养基,30 ℃、180 r/min培养12 h后加入硒母液使硒质量浓度为30 μg/mL。发酵结束后离心、洗涤菌体,并用真空冷冻干燥机冻干,测量其富硒量及生物量。
1.3.4 W1酵母菌种的鉴定
形态学观察:将菌株接种至YPD固体培养基上,30 ℃条件下培养3 d,观察菌落的颜色及在显微镜下的细胞形态。
分子生物学鉴定:采用试剂盒提取酵母的基因组DNA,以提取的基因组DNA为模板,NS1f:5′-GTAGTCATATGCTTGTCTC-3′和NS8r:5′-TCCGCAGGTTCACCTACGGA-3′为引物扩增W1酵母的18S rDNA基因[12]。
1.3.5 酵母富硒量的测定
在酸性环境中,硒与3,3′-二氨基联苯胺(3,3′-diaminobenzidine,DAB)发生反应,生成一种黄色的硒-苤脑络合物。在中性条件下,该络合物容易被甲苯或二甲苯进行萃取,并且在420 nm的波长下呈现最大吸光度[13]。最终以硒浓度为横坐标、420 nm吸光度为纵坐标绘制标准曲线,得到回归方程Y=0.018 7X+0.031 9,相关系数为0.999的标准曲线,表明硒质量浓度在0~100 μg/mL范围内线性良好。
1.3.6 酵母生物量的测定
菌体生物量采用称重法测定,将真空冷冻干燥得到的富硒酵母冻干粉置于天平上准确称量。
1.3.7 富硒酵母的发酵工艺优化
以糖蜜浓度25 °Bx,硫酸铵3.0 g/L,硒添加量30 μg/mL,发酵时间36 h为初始发酵条件,分别考察糖蜜浓度(15、20、25、30 °Bx)、硫酸铵添加量(1、3、5、7 g)、硒添加量(10、20、30、40、50 μg/mL)及发酵时间(24、36、48、60 h)对酵母富硒能力的影响。分别选取富硒酵母发酵条件中对酵母富硒影响最为显著的3个因素(糖蜜浓度、硫酸铵添加量及发酵时间)为考察因素,以硒转化率为响应值,设计了3因素3水平响应面分析实验(表1),进一步优化发酵条件。
表1 因素水平表
Table 1 Factor level table

水平因素A(糖蜜浓度)/°BxB(硫酸铵添加量)/gC(发酵时间)/h-115136020348125560
1.3.8 富硒酵母抗氧化活性的检测
以DPPH自由基清除率、羟自由基及超氧阴离子自由基清除率为指标分别探究超声波提取法[14]、酶解法[15]、超声波协同酶解法与未处理菌株的体外抗氧化能力,选用最佳处理方法研究不同发酵时间富硒酵母的体外抗氧化活性。
1.4 数据处理
本文中所有实验均平行测定3次,采用Excel 2019进行数据处理,MEGA 11、Origin 2022、Design Expert 13.0及SPSS 26.0软件进行数据分析与制图,所有数据以“平均值±标准差”的形式呈现。
2 结果与分析
2.1 菌种的筛选
2.1.1 菌种的初筛
通过红硒法与耐硒法相结合,从实验室保存的35株酵母中初步筛选出7株长势较好且颜色较淡的酵母菌株,分别为W1、W2、W3、W4、W5、W9、W10。由表2可知,随着硒浓度的增加,酵母菌体量呈现逐步减少的趋势,当硒质量浓度达到50 μg/mL时,W1、W3、W4、W5的酵母菌体沉淀量相较于未添加硒的菌体沉淀量变化较少,表明这4株酵母菌对亚硒酸钠的耐受性较强。
表2 不同硒浓度酵母菌体量与颜色对比
Table 2 Comparison of yeast biomass and color at different selenium concentrations

菌株编号筛选方法硒质量浓度/(μg/mL)01020304050W1耐硒法/////////////////////////红硒法++++++++++++++++++++++++++W2耐硒法/////////////////////红硒法+++++++++++++++++++++W3耐硒法//////////////////////红硒法++++++++++++++++++++++W4耐硒法////////////////////////红硒法++++++++++++++++++++++++W5耐硒法//////////////////////红硒法+++++++++++++++++++++++W9耐硒法/////////////////////红硒法++++++++++++++++++W10耐硒法/////////////////////红硒法+++++++++++++++++++
注:“//////”表示正常酵母菌体的沉淀量;“/////”表示正常酵母菌体沉淀量的5/6;“////”表示正常酵母菌体沉淀量的4/6;“///”表示正常酵母菌体沉淀量的3/6;“//”表示正常酵母菌体沉淀量的2/6;“/”表示正常酵母菌体沉淀量的1/6;“+++++”表示正常酵母菌体颜色;“++++”表示菌体颜色浅粉;“+++”表示菌体颜色粉红;“++”表示菌体颜色微红;“+”表示菌体颜色红。
随着硒浓度的增加,酵母菌体颜色逐渐变深,当硒质量浓度达到50 μg/mL时,W1、W3、W4、W10酵母菌体颜色相较于其他菌株颜色较浅,均为微红色,其余菌种皆为红色,表明这4株酵母菌株对亚硒酸钠的转化能力较强[7]。结合红硒法与耐硒法,选用W1、W3及W4酵母菌株进行摇瓶发酵实验复筛进一步验证。
2.1.2 菌种的复筛
将W1、W3和W4酵母菌株以5%的接种量分别接种至糖蜜基础培养基中进行富硒发酵,酵母富硒含量如图1所示,W1、W3及W4酵母菌株的富硒量分别为943.25、726.51、626.02 μg/g,生物量分别为8.07、7.96、8.1 g/L,硒转化率分别为25.37%、19.28%及16.9%。此结果表明,W1酵母菌株在30 μg/mL的硒浓度下富硒能力最强,因此选用W1酵母菌株作为后续实验菌株。

图1 酵母菌种的复筛
Fig.1 Rescreening of yeast strains
注:不同字母代表存在显著差异(P<0.05)(下同)。
2.2 酵母菌种的鉴定
2.2.1 形态学鉴定
通过观察酵母在培养基上的形态,W1酵母菌落大而厚且呈乳白色,表面光滑且明亮,具有浓郁的酵母风味和酯香味,符合酵母菌的菌落特征及其独特气息(图2-a);通过显微镜观察,酵母菌细胞呈圆形状,其中一些细胞正经历着芽殖分裂的过程,符合酵母无性繁殖的显著特征(图2-b);初步判定W1菌株为酵母菌。
a-酵母菌落形态;b-酵母显微镜形态
图2 酵母菌落形态及显微镜形态(10×40倍)
Fig.2 Morphology of yeast colonies and microscopic observation (10×40 magnification)
2.2.2 分子生物学鉴定
W1酵母菌株18S rDNA基因PCR扩增结果如图3所示:条带亮度较高,基因片段大小为1 800 bp左右,与目的产物大小相符,表明PCR扩增所得产物可用于后续的序列测定。将18S rDNA基因扩增产物送至生工生物工程(上海)股份有限公司测序,运用BLAST同源性分析基因测序结果,构建系统发育树。结果如图4所示,W1酵母菌株与酿酒酵母在同一进化分支,同源性最高。因此,将W1酵母菌株鉴定为酿酒酵母。

图3 W1酵母菌株PCR扩增电泳图
Fig.3 PCR amplification electrophoresis of yeast strain W1

图4 基于18S rDNA基因序列构建的菌株W1的系统发育树
Fig.4 Phylogenetic tree of strain W1 constructed based on 18S rDNA gene sequence
2.3 富硒酵母的发酵工艺优化
2.3.1 不同糖浓度对酵母富硒的影响
糖蜜是影响酵母富硒的主要因素之一,其浓度的高低对酵母的生长速度和代谢活性具有显著影响。由图5可知,当糖蜜浓度为20 °Bx时,酵母的富硒量及生物量达到最大值;而为25~30 °Bx时随着糖蜜浓度逐渐增大,富硒量、生物量及硒转化率逐渐减小,可能是因为高糖浓度通过改变渗透压、代谢途径以及抑制细胞生长等方式,对酵母细胞转化硒产生了负面影响[16],因此选择20 °Bx作为培养基的糖蜜浓度。

图5 不同糖浓度对W1酵母富硒的影响
Fig.5 Effect of different sugar concentrations on selenium-enrichment of yeast W1
2.3.2 不同硫酸铵添加量对酵母富硒的影响
硫酸铵作为氮源,在富硒酵母培养过程中起到了促进酵母生长的重要作用。同时,它也是构成酵母细胞中蛋白质、核酸、酶等成分的重要物质,对富硒酵母的发酵与硒含量富集具有显著影响。由图6可知,当硫酸铵添加量为3 g/L时,酵母的富硒量及生物量达到最大值;而随着硫酸铵添加量的增大,富硒量、生物量及硒转化率逐渐减小,这可能是因为过量的硫酸铵对酵母产生了抑制作用,从而导致酵母的生长受到阻碍[17]。因此选择3 g/L添加量作为培养基的硫酸铵添加量。

图6 不同硫酸铵添加量对W1酵母富硒的影响
Fig.6 Effect of different ammonium sulfate concentrations on selenium-enrichment of yeast W1
2.3.3 不同硒添加量对酵母富硒的影响
硒添加量在酵母富硒过程中起到了决定性的作用,适当的硒添加量可以使酵母高效地吸收并转化硒,从而提高硒的富集效率。由图7可知,随着硒添加量在10~50 μg/mL内增大,酵母富硒量随着硒添加量的增大而增加,生物量则随着硒添加量的增大而减小,这种结果是因为硒具有较大的毒性,高浓度的无机硒会影响酵母的正常代谢,抑制酵母的生长发育,使得酵母的富硒量及生物量下降[18]。因此选择40 μg/mL作为酵母富硒培养的硒质量浓度。

图7 不同硒添加量对W1酵母富硒的影响
Fig.7 Effect of different selenium addition levels on selenium-enrichment of yeast W1
2.3.4 不同发酵时间对酵母富硒的影响
发酵时间会直接影响酵母的生长繁殖与硒含量,在适宜的发酵时间内,酵母细胞能够充分利用营养物质进行生长和繁殖。由图8可知,当发酵时间为24~48 h时,酵母富硒量及生物量随着发酵时间的延长而缓步增加,当发酵时间为48 h时,富硒量及生物量达到最大值;而在发酵时间为60 h时,酵母的富硒量及生物量低于48 h。这可能是因为随着发酵时间的延长,发酵液中的营养成分消耗殆尽,从而影响其对硒的富集能力[19]。因此选择适宜酵母生长和富硒的48 h作为富硒发酵培养的时间。

图8 不同发酵时间对W1酵母富硒的影响
Fig.8 Effect of different fermentation time on selenium-enrichment of yeast W1
2.3.5 响应面法优化富硒酵母的发酵工艺
响应面优化法是一种运用统计学手段构建响应面模型,对多个设计变量进行系统优化,以期确定一组最优设计参数的方法。由表3响应面优化结果和表4方差分析可知,表中回归模型“P”值为0.000 3,极显著,表中相关模型系数R2为0.964 8,校正系数模型![]() 为0.919 5,表明模型准确度高,可用该模型对真实情况进行预测。对所得硒转化率进行回归拟合,得到多项回归方程:硒转化率=52.73+0.251 3A-0.256 2B+0.195 0C-0.695 0AB-0.207 5AC+0.277 5BC-1.28A2-1.78B2-1.58C2。
为0.919 5,表明模型准确度高,可用该模型对真实情况进行预测。对所得硒转化率进行回归拟合,得到多项回归方程:硒转化率=52.73+0.251 3A-0.256 2B+0.195 0C-0.695 0AB-0.207 5AC+0.277 5BC-1.28A2-1.78B2-1.58C2。
表3 响应面优化结果
Table 3 Results of response surface optimization

编号A糖蜜浓度/°BxB硫酸铵添加量/gC发酵时间/h硒转化率/%12536050.4522034852.2432056049.3141533648.8852013649.9862034853.0871536050.2882053648.9692554848.9102514850.85112533649.88121554849.87132034852.62141514849.04152034852.49162034853.21172016049.22
表4 硒转化率方差分析
Table 4 Variance analysis of selenium conversion rate

系数平方和自由度均方F值Prdb>F显著性模型38.0394.2321.300.000 3**A-糖蜜浓度0.505 010.505 02.550.154 7B-硒含量0.525 310.525 32.650.147 7C-发酵时间0.304 210.304 21.530.255 5AB1.9311.939.740.016 8*AC0.172 210.172 20.868 00.382 5BC0.308 010.308 01.550.252 9A26.8916.8934.720.000 6**B213.40113.4067.540.000 1**C210.46110.4652.740.000 2**残差1.3970.198 4失拟项0.726 230.242 11.460.351 3不显著纯误差0.662 740.165 7总差异39.4216R2=0.964 8R2adj=0.919 5
注:P<0.05,“*”表示差异显著;P<0.01,“**”表示差异极显著。
模型一次项A(糖蜜浓度)、B(硫酸铵添加量)、C(发酵时间)的“P”值大于0.05,表明其对硒转化率的影响是不显著的;二次项AB的“P”值小于0.05,表明其对硒转化率的影响是显著的;二次项中的A2,B2,C2的“P”值小于0.01,表明其对硒转化率的影响是极显著的。由此可得,因素对响应值的影响较为复杂,不是简单的线性关系。
通过响应面分析软件对不同因素之间的交互作用进行系统分析并绘制响应面曲线图。图9~图11分别显示了糖蜜浓度、硫酸铵添加量与发酵时间这3个因素以硒转化率为响应值的趋势图,其中糖蜜浓度和硫酸铵添加量、糖蜜浓度和发酵时间、硫酸铵添加量与发酵时间的等高线近似椭圆,说明其因素之间的交互效应对响应值影响显著。

a-平面图;b-3D图
图9 糖蜜浓度与硫酸铵浓度对酵母富硒的影响
Fig.9 Effect of molasses concentration and ammonium sulfate concentration on selenium-enrichment of yeast

a-平面图;b-3D图
图10 糖蜜浓度与发酵时间对酵母富硒的影响
Fig.10 Effect of molasses concentration and fermentation time on selenium-enrichment of yeast

a-平面图;b-3D图
图11 硫酸钠添加量与发酵时间对酵母富硒的影响
Fig.11 Effect of sodium sulfate addition and fermentation time on selenium-enrichment of yeast
通过建立的回归模型可以得到,优化后的培养基组分为:糖蜜浓度20.60 °Bx,硫酸铵添加量2.82 g/L,发酵时间48.56 h,最终可得到硒转化率为52.76%。在此条件下进行3组验证实验,得到硒含量为2 196.81 μg/g,生物量9.60 g/L,硒转化率52.72%。
2.4 富硒酵母抗氧化活性的测定
2.4.1 不同处理方式对富硒酵母抗氧化活性的影响
破壁是提高酵母抗氧化活性的关键步骤,而破壁方式的选择对于酵母的抗氧化活性具有显著影响。由图12可知,而超声协同酶解法在DPPH自由基、羟自由基及超氧阴离子自由基清除率上最优,分别为57.16%、45.79%和27.35%,富硒酵母中各抗氧化活性大小排序为:DPPH自由基清除率>超氧阴离子自由基清除率>羟自由基清除率。

图12 不同处理方式对富硒酵母抗氧化活性的影响
Fig.12 Effect of different processing methods on antioxidant activity of selenium-enriched yeast
注:“*”表示P<0.05,“**”表示P<0.01。
综上,通过研究不同处理方式对富硒酵母抗氧化活性的影响,结果表明3种方法均显现出较好的抗氧化活性,超声波协同酶解法是富硒酵母抗氧化活性处理的最优方法。酵母经过超声协同酶解后抗氧化活性增加,这可能因为超声处理提高抗氧化酶的活性、增强酵母β-葡聚糖的可溶性,也可能是因为超声协同酶解提高酵母多肽得率和水解度,从而提高了酵母的抗氧化活性[20]。
2.4.2 不同发酵时间对富硒酵母抗氧化活性的影响
酵母的抗氧化活性可以增强生物体抗氧化能力,由图13可知,随着发酵时间的延长,富硒酵母的羟自由基、超氧阴离子自由基及DPPH自由基清除率呈现上升的趋势。当发酵48 h时,酵母的羟自由基、超氧自由基及DPPH自由基清除率最高,分别为57.66%、44.35%及26.54%,与陈历水等[21]的研究结论相似。综上,富硒酵母在发酵24~60 h时具有一定的抗氧化活性,发酵至48 h时抗氧化活性最高,这可能是富硒酵母中的硒蛋白发挥了作用[22]。

图13 不同发酵时间对富硒酵母抗氧化活性的影响
Fig.13 Effect of different fermentation time on antioxidant activity of selenium-enriched yeast
3 结论
本研究从土壤及果蔬样品中筛选出1株富硒能力强、生物量高的W1酿酒酵母。通过响应面优化得到富硒酵母的最优发酵工艺为:糖蜜浓度20.60 °Bx,硫酸铵添加量2.82 g/L,发酵时间48.56 h,最终可得到富硒酵母的硒含量为2 196.81 μg/g,生物量9.60 g/L,硒转化率52.72%,与未优化前相比,硒含量提高了1.55倍,硒转化率提高了1.17倍。W1菌株展现出显著的无机硒转化能力,与先前研究中关于优化富硒酵母发酵工艺可以显著提高硒含量及生物量报道相一致并处于领先水平[23]。
此外,富硒酵母还具有一定的抗氧化活性,这一研究结论与富硒酵母具有增强抗氧化防御系统的能力相吻合[24]。为了深入探究W1酵母菌株的抗氧化性能,本研究以羟自由基、超氧阴离子自由基及DPPH自由基清除率为评价指标,分别考察不同处理方式(超声波提取法、酶解法、超声波协同酶解法)及不同发酵时间(24、36、48、60 h)对其体外抗氧化能力的影响。结果表明,超声波提取法、酶解法、超声波协同酶解法处理富硒酵母均显现出较好的抗氧化活性,其中超声波协同酶解法是富硒酵母抗氧化活性处理的最优方法。富硒酵母在不同发酵时间均具有一定的抗氧化活性,而在发酵至48 h时抗氧化活性最高,这一发现与周娜[25]研究结论相一致。综上所述,本研究筛选出的W1酿酒酵母对无机硒的转化能力较强,具有显著抗氧化活性,在工业化生产中拥有良好的应用前景。
[1] 覃新云, 农可懿, 吕其壮, 等.微量元素硒的抗氧化作用研究进展[J].中国食品添加剂, 2022, 33(10):272-278.QIN X Y, NONG K Y, LYU Q Z, et al.Research progress of the antioxidant effects of trace element selenium[J].China Food Additives, 2022, 33(10):272-278.
[2] EWUOLA O E, AKINYEMI E D.Reproductive potential of rabbit bucks orally administered exogenous organic selenium[C].The Proceedings of the British Society of Animal Science (Annual Conference).Chester:British Society of Animal Science, 2015.
[3] LIAO Q, YAN C, HUANG N B, et al. Progress in selenium and genetics associated with Keshan disease[J]. Journal of Trace Elements and Minerals, 2024, 7:100107.
[4] BODNAR M, KONIECZKA P.Evaluation of candidate reference material obtained from selenium-enriched sprouts for the purpose of selenium speciation analysis[J].LWT, 2016, 70:286-295.
[5] 陈析羽, 张浩, 汤虎, 等. 富硒食品的研究进展与展望[J]. 中国食物与营养, 2018, 24(6):11-14.CHEN X Y, ZHANG H, TANG H, et al. Research progress and prospect of selenium-enriched food[J]. Food and Nutrition in China, 2018, 24(6):11-14.
[6] DU C D, ZHU S, LI Y, et al.Selenium-enriched yeast, a selenium supplement, improves the rheological properties and processability of dough:From the view of yeast metabolism and gluten alteration[J].Food Chemistry, 2024, 458:140256.
[7] 杨新, 陈莉, 杨双全, 等.开阳地区桑葚果园富硒酵母菌的分离、筛选及鉴定[J].食品与发酵工业, 2020, 46(24):66-73.YANG X, CHEN L, YANG S Q, et al.Isolation, screening and identification of selenium-enriched yeast from mulberry orchard of Kaiyang[J].Food and Fermentation Industries, 2020, 46(24):66-73.
[8] 马楚楚, 陈帅君, 赵宝顶, 等. 产朊假丝酵母富硒条件的优化及发酵罐培养[J]. 天津农学院学报, 2022, 29(4):26-30; 35.MA C C, CHEN S J, ZHAO B D, et al. Optimization of selenium enrichment condition and culture of Candida utilis in fermenter[J]. Journal of Tianjin Agricultural University, 2022, 29(4):26-30; 35.
[9] 贺莹, 赵建英, 母焱楠.响应面法优化富硒酵母的营养条件优化[J].食品工业, 2017, 38(12):30-34.HE Y, ZHAO J Y, MU Y N.Optimization of yeast enriching selenium fermentation by response surface method[J].The Food Industry, 2017, 38(12):30-34.
[10] 张斌. 富硒酵母抗氧化活性的初步研究[J]. 蚌埠学院学报, 2014, 3(3):18-20; 28.ZHANG B. Research on antioxidative activity of selenium enriched yeast[J]. Journal of Bengbu College, 2014, 3(3):18-20; 28.
[11] 冯星, 贺绍君, 刘德义.夏季饲粮中添加富硒酵母对皖东黄牛体重、血常规、血清生化指标和抗氧化功能的影响[J].动物营养学报, 2022, 34(8):5116-5125.FENG X, HE S J, LIU D Y.Effects of dietary adding selenium-rich yeast on weight, blood routine, serum biochemical indexes and antioxidant function of wandong cattle in summer[J].Chinese Journal of Animal Nutrition, 2022, 34(8):5116-5125.
[12] 葛达娥. 丁香酚对链格孢霉的抑制作用及其在蓝莓保鲜中的应用[D].上海:上海海洋大学, 2020.GE D E.The inhibitory of eugenol against Alternaria sp.and its application in blueberry preservation[D].Shanghai:Shanghai Ocena University, 2020.
[13] 江宝瑞. 富硒酵母的筛选、抗氧化活性检测及硒检测的方法学优化[D].江西:宜春学院, 2022.JIANG B R.Screening of Selenium-rich yeast, detection of antioxidant activity and methodological optimization of selenium detection[D].Jiangxi:Yichun University, 2022.
[14] MENG Y Y, LIANG Z Q, YI M, et al.Enrichment of zinc in Lactobacillus plantarum DNZ-4:Impact on its characteristics, metabolites and antioxidant activity[J].LWT, 2022, 153:112462.
[15] 朱华健, 陈皓, 李宛格, 等. 高鲜酵母抽提物的制备及产品性质分析[J]. 食品与发酵工业, 2025, 51(12):11-20.ZHU H J, CHEN H, LI W G, et al. Preparation and performance of high-freshness yeast extract[J]. Food and Fermentation Industries, 2025, 51(12):11-20.
[16] 朱昌雄. 利用酿酒酵母菌富集硒的研究[D].武汉:华中农业大学,2007.ZHU C Q.study on selenium-enrichment by Saccharomyces cerevisiae[D].Wuhan:Huazhong Agricultural University, 2007.
[17] 张乐. 耐硫酸铵酿酒酵母的筛选及机理初探[D].内蒙古:内蒙古工业大学, 2023.ZHANG L.Screening of ammonium sulfate resistant Saccharomyces cerevisiae and its mechanism[D].Inner Mongolia:Inner Mongolia University of Technology, 2023.
[18] KIELISZEK M, ![]() S, BZDUCHA-WR
S, BZDUCHA-WR BEL A, et al. Effect of selenium on growth and antioxidative system of yeast cells[J]. Molecular Biology Reports, 2019, 46(2):1797-1808.
BEL A, et al. Effect of selenium on growth and antioxidative system of yeast cells[J]. Molecular Biology Reports, 2019, 46(2):1797-1808.
[19] 赖颖, 赵锦慧, 王靖宇. 发酵性结合酵母菌的富硒能力的研究[J]. 饲料研究, 2015, 38(6):25-28; 47.LAI Y, ZHAO J H, WANG J Y. Study on selenium-enriched ability of fermentative combined yeast[J]. Feed Research, 2015, 38(6):25-28; 47.
[20] MA X, DONG L, HE Y, et al. Effects of ultrasound-assisted H2O2 on the solubilization and antioxidant activity of yeast β-glucan[J]. Ultrasonics Sonochemistry, 2022, 90:106210.
[21] 陈历水, 马莺, Jean-Louis MAUBOIS, 等. 乳源酵母Pichia fermentans的抗氧化特性[J]. 哈尔滨工业大学学报, 2010, 42(2):292-296.CHEN L S, MA Y, MAUBOIS J, et al. Antioxidant activity of Pichia fermentans isolated from raw milk[J]. Journal of Harbin Institute of Technology, 2010, 42(2):292-296.
[22] WANG J, ZHANG J Y, ZHONG Y T, et al.Sex-dimorphic distribution and anti-oxidative effects of selenomethionine and Se-methylselenocysteine supplementation[J].Journal of Food Science, 2021, 86(12):5424-5438.
[23] 蔡飞, 高飞飞, 王斌, 等.富硒酵母的分离鉴定及富硒条件的优化[J].中国酿造, 2018, 37(6):103-108.CAI F, GAO F F, WANG B, et al.Isolation and identification of selenium-enriched yeast and optimization of selenium-enriched conditions[J].China Brewing, 2018, 37(6):103-108.
[24] CHEN Y Q, HE H R, BI X J, et al.Effects of various selenium-enriched yeasts, selenomethionine, and nanoselenium on production performance, quality, and antioxidant capacity in laying hens[J].Poultry Science, 2024, 103(3):103387.
[25] 周娜. 硒酵母生长条件优化及其抗氧化活性研究[D].湖北:湖北工业大学, 2015.ZHOU N.Optimization of Se-yeast growth conditions and research of antioxidant activity[D].Hubei:Hubei University of Technology, 2015.